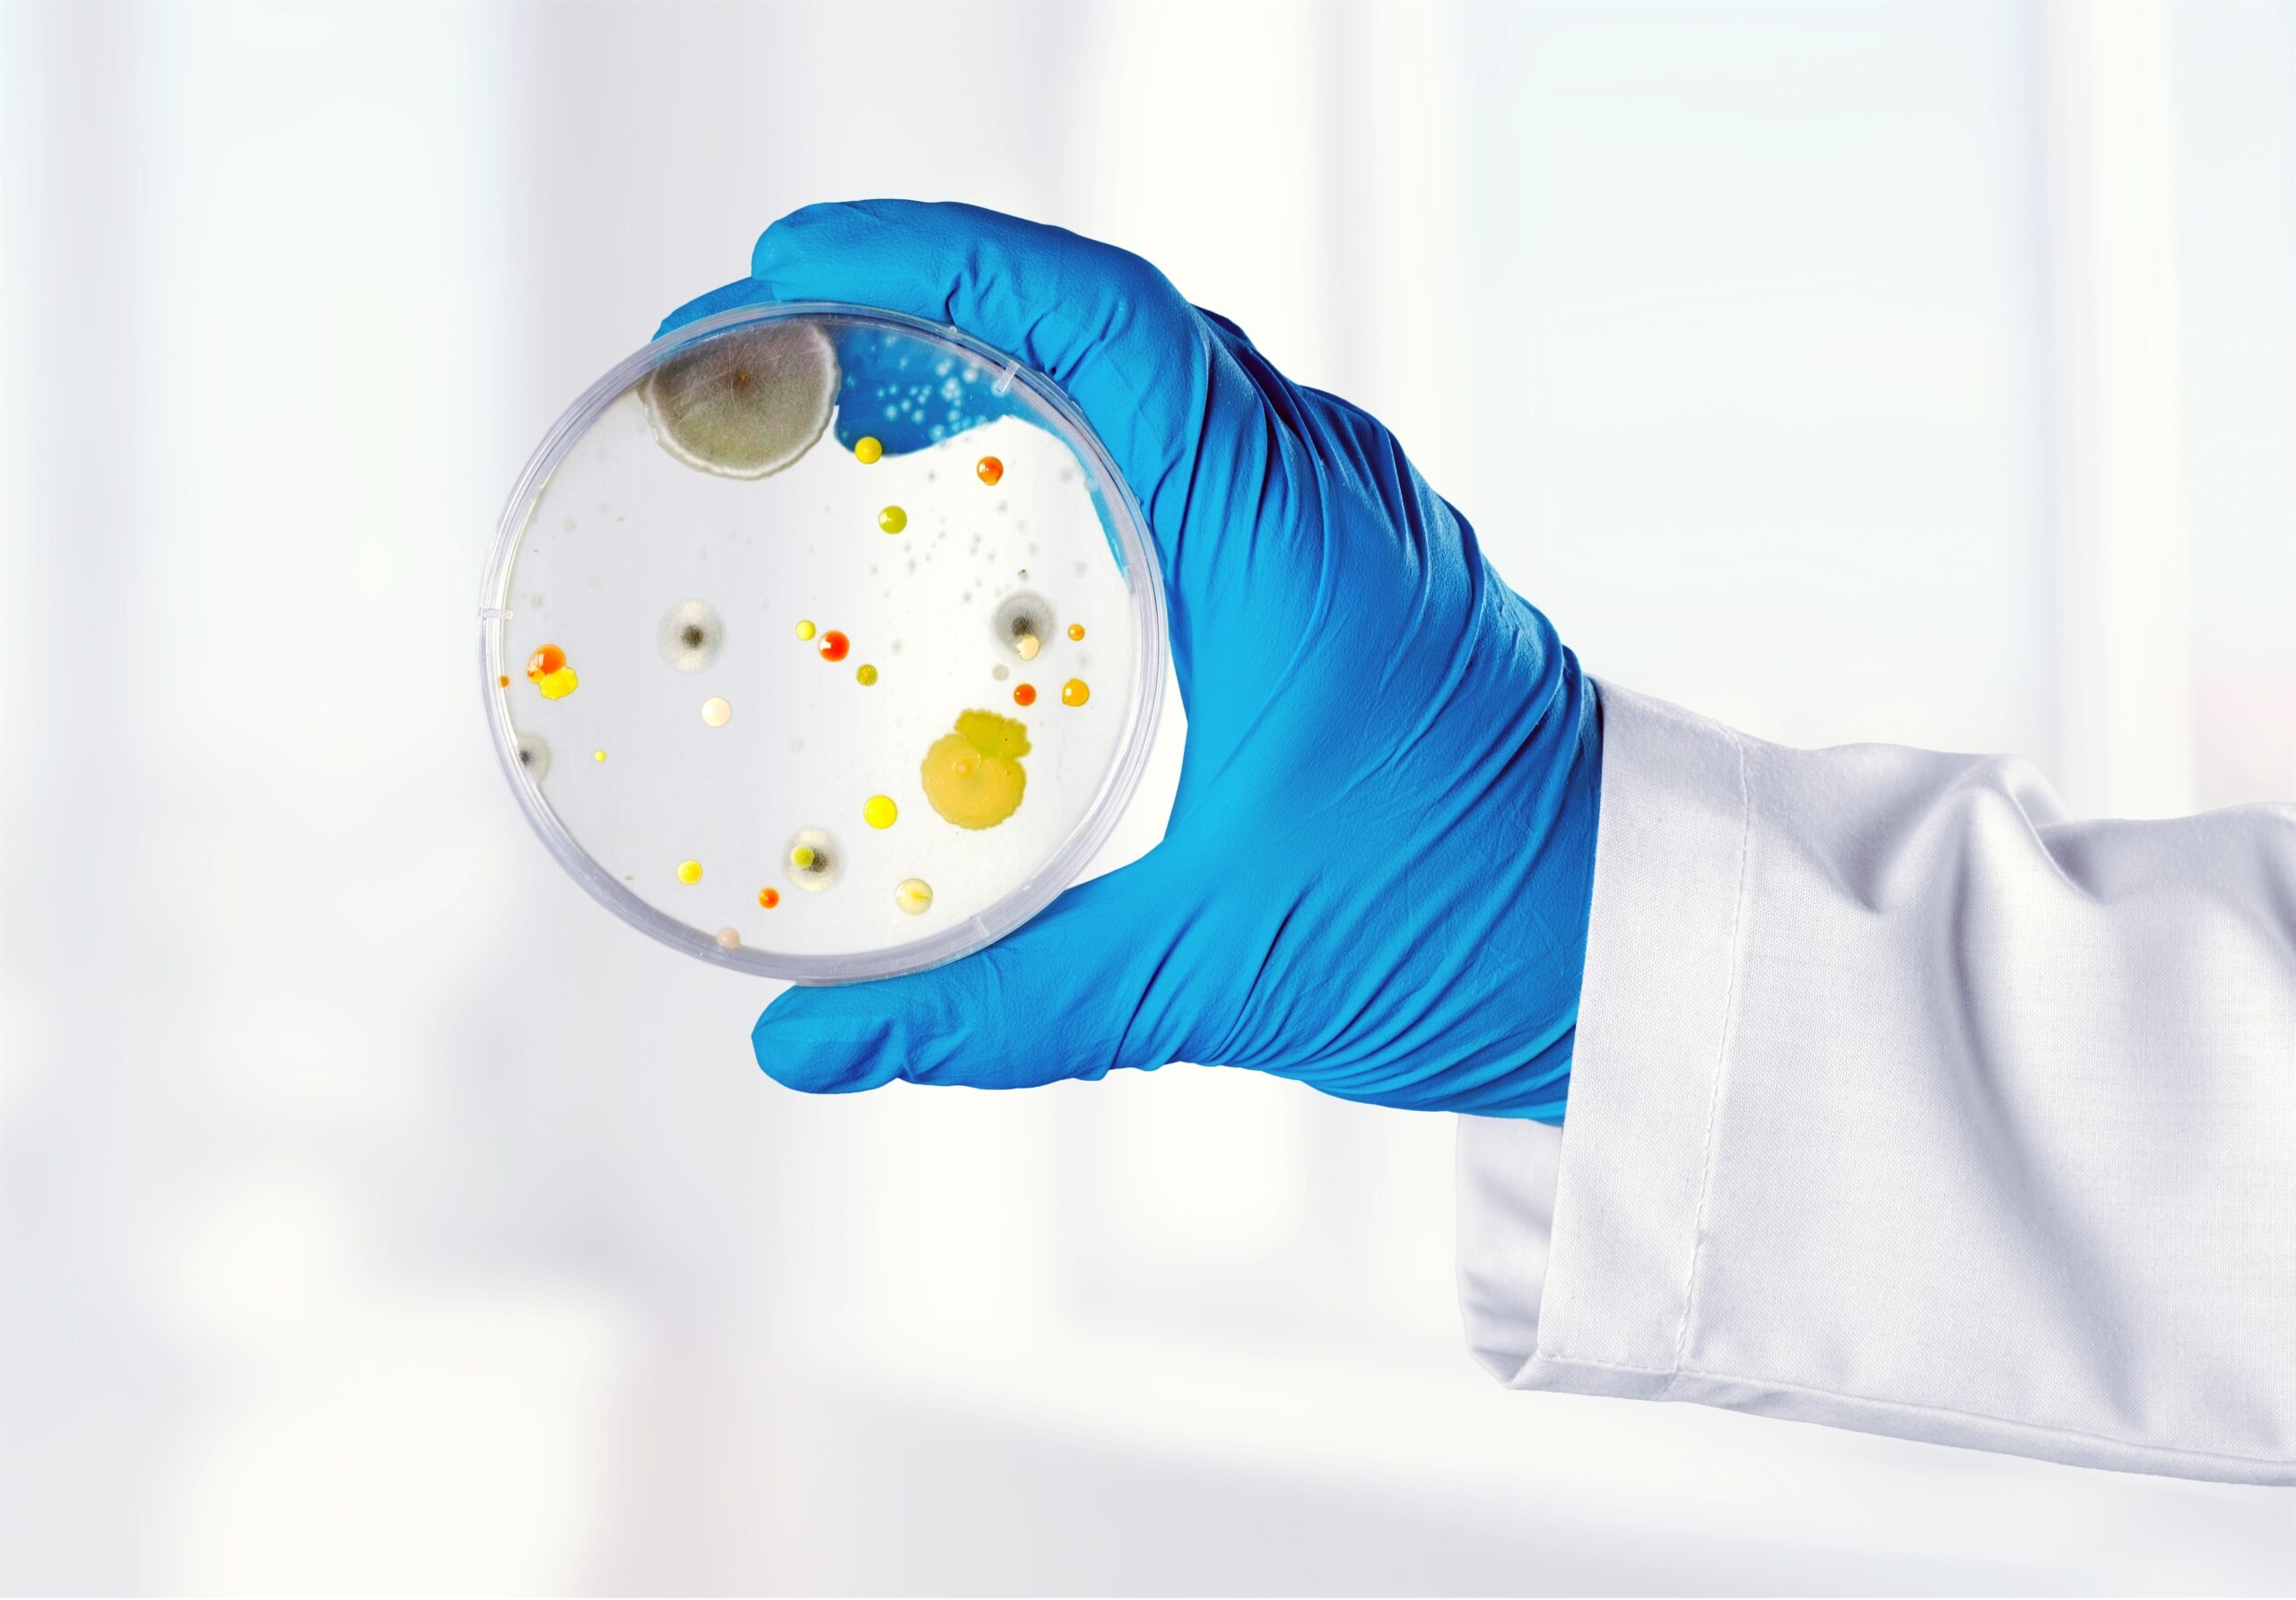
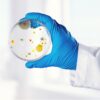

Description
The i-know kit makes the invisible visible by scientifically proving how effective and thorough the i-range products clean. The collected data helps you get more insights in the cleaning process, making future cleaning operations more efficient.